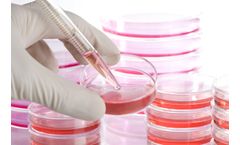
Inovarion - Cellular and Molecular Biology Technology

- Home
- Equipment
Refine by
Inovarion Environmental Equipment & Supplies
2 equipment items found
Manufactured by:Inovarion based inParis, FRANCE
A biosensor is a device for the detection of a chemical substance by the combination of a biological component and a physico-chemical detector. The sensitive biological component interacts, binds or recognizes the product under study. The detector element of the device transforms the interaction of the analyte with the biological element into a detectable and quantifiable signal. Furthermore, ...
Manufactured by:Inovarion based inParis, FRANCE
Cellular and molecular biology explores the links between cellular functions and associated mechanisms at the molecular level. Thus, the fields of application of molecular biology are ...